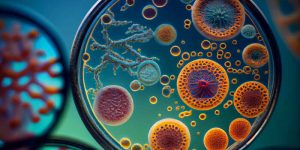
micro-organism-magnified-reveal-molecular-structure-generated-by-ai

Cancer research
PLOS supports community-driven publishing of articles covering a wide spectrum of topics in all areas of cancer treatment and research, including oncology, immunotherapy, cancer diagnostics, screening, cancer translational studies, and much more.
Stay up to date on cancer research from PLOS
Explore cancer research from PLOS
Cancer research has the potential to transform and save lives by developing safe and effective ways to prevent, detect, diagnose, treat and ultimately cure the spectrum of diseases called cancer.
PLOS has been instrumental in advancing the understanding of cancer by providing an open platform for researchers to share their findings and facilitating the rapid dissemination of crucial information related to cancer biology, prevention, diagnosis, treatment, and survivorship.
PLOS journals not only cover a wide range of topics within cancer research, including tumor biology, immunotherapy, precision medicine, and clinical trials, but also encourage transparency and reproducibility in scientific research, essential principles in cancer research to ensure the validity and reliability of findings.
Research spotlights
As a leading publisher in the field, these articles showcase research that has influenced academia, industry and/or policy.
Cancer research topics
PLOS publishes research across a broad range of topics. Take a look at the latest work in your field.
Explore the latest research developments in your field
Our commitment to open science means others can build on cancer research and data to advance the field. Discover selected popular research below:
Predicting the burden of cancer in Switzerland up to 2025
PLOS Global Public Health
Browse the full PLOS portfolio of open access cancer articles
51,827 authors from 158 countries chose PLOS to publish their cancer research*
Reaching a global audience, this research has received over 12,180 news and blog mentions^
Research in this field has been cited 57,587 times
after authors published in a PLOS journal*
Related PLOS research collections
Covering a connected body of work and evaluated by leading experts in their respective fields, our collections make it easier to delve deeper into specific research topics from across the breadth of the PLOS portfolio.
Check out our highlighted PLOS research collections:
Related journals in cancer
We provide a platform for cancer research across various PLOS journals, allowing interdisciplinary researchers to explore cancer at all preclinical, translational and clinical research stages.
*Data source: Web of Science. © Copyright Clarivate 2024 | January 2004 – June 2024
^Data source: Altmetric.com | January 2004 – June 2024